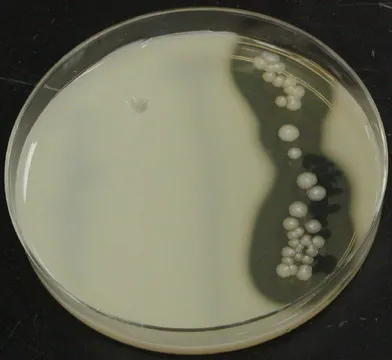

Big news for @SteemSTEM this month as their new website (https://steemstem.io) just launched. This could be the start of turning this community into major platform of scientific communication and I couldn’t be more excited. If you’re reading this on Steemit, I encourage you to check out this article on steemstem.io to give it a try.
To celebrate this occasion, I want to write a series of posts on the recently announced 2018 Nobel Prize in Chemistry. This year’s prize was awarded to Frances H. Arnold for pioneering the first directed evolution of enzymes, and to George P. Smith and Sir Gregory P. Winter for developing phage display 1. The award was a major story in a bunch of news outlets, but I found most of the pieces were scant on details. They only gave a cursory overview of the techniques that the scientists spent a major portion of their lives developing. Fortunately, @SteemSTEM has given me the platform to remedy that problem. Each entry in this series will focus on one of the scientists’ contributions, try to explain that contribution and show why the scientist deserves this prize. Today’s focus: Frances H. Arnold and directed evolution.
Who is She?

Frances Arnold is an extraordinary scientist 2. For the past 25 years, her research has created and developed and entirely new branch of biology known as directed evolution. Her work has been widely lauded with numerous awards and many other labs pushing her work even further. She currently works in the chemical engineering department of the California Institute of Technology and still runs an active lab with a robust publication record.
It’s surprisingly difficult to explain what kind of scientist she is. Most news articles refer to her as a chemist and her department at CalTech is the department of chemical engineering so you can use those fields to explain her profession 3. However, it’s probably more accurate to call her a biochemist or molecular biologist given the bulk of her work is on the chemistry within living organisms. I was also surprised to find that her career actually began in mechanical engineering, 4 and she initially developed directed evolution as a means to improve chemical reactions. It’s possible that her unusual background gave her the outside-the-box thinking to discover the new technique. At any rate, I think it’s pretty safe to say that her ability to find success in a traditionally male dominated field means she must be one hell of a good scientist, regardless of the field.
Frances Arnold (2)
What did she do?
In 1993, Dr. Arnold published the PNAS paper “tuning the activity of an enzyme for unusual environments: sequential random mutagenesis of subtilisin E for catalysis in dimethylformamide” 5. It’s a little bit hard at first to see why such a paper is so important. PNAS is a prestigious journal, but the title of this article is pretty innocuous. The enzyme it mentions, subtilisin E, is of minimal importance, and all the paper claims to have done is increase the stability of this enzyme. However, the true value of this paper is all about to be how this feat was accomplished: The “sequential random mutagenesis.”
This technique, which eventually became known as directed evolution, was an attempt to improve an enzyme through genetic engineering in the most efficient way possible. During this era in science, researchers could get the amino acid sequence of an enzyme of interest, but it still wouldn’t tell them all they wanted to know about an enzyme. Determining which amino acids were critical to stability and which ones comprised the active site was a chore (and still is today) 5.5. If the researchers wanted to improve upon the enzyme, they would have to choose (or perhaps guess) which amino acids to mutate. Making those specific mutations was then a long and laborious process. Dr. Arnold decided to take out the guessing and extensive labor by letting randomness take over.
The core process of directed evolution in this paper is to create thousands of bacterial strains, each with a unique of variant of subtilisin E, that can be quickly screened for stability. This requied three main steps: Creating the variant genes, transforming bacteria with the variants, and screening the proteins for stability

Generic overview of directed evolution. Adapted from 6
Creating variants
In this step, Dr. Arnold used PCR to generate millions of variant copies of the subtilisin E gene. PCR is a technique in which a stretch of DNA can be amplified many times and has been covered on Steemit in great detail 7. It’s usually very accurate, but Dr. Arnold didn’t want accuracy in this case. Instead, she wanted the amplification step to make a random error every few thousand base pairs. In this way, every gene amplified would be expected to have one or two mutations on average. She did this by essentially mixing a bad PCR reaction. She modified the components so that the polymerase just didn’t work as well as it usually does and put the wrong base pair in on occasion. Thus, thousands of subtilisin E gene variants were created within several hours.
Transforming cells
Dr. Arnold was working with B. subtilis, a Gram positive bacteria grows quickly and transforms easily. I worked with B. subtilis for 5 years in graduate school and can confirm that the organism was perfect for this experiment. All she had to do is ligate the gene variants to a plasmid and mix the ligation with growing cells. Plate those bacteria after a few hours on selective media and you’ll find hundreds of transformed colonies the next day.
screening variants
I’ll let Dr. Arnold’s paper explain why the variant screen was so easy.
Active subtilisin secreted from the bacterial cells will hydrolyze casein, creating visible halos on agar plates containing 1% casein. The secreted enzyme can be picked up on a nitrocellulose filter and transferred to DMF-containing plates to screen for activity in DMF without damaging the B. subtilis host
In other words, she could look at the colonies growing on plates with casein and the dimethylformamide she is screening for. Casein is cloudy, and when bacteria hydrolyze it, the agar becomes clear. Thus, they could visibly see which transformants showed high subtilisin activity by looking for large halos around the colonies. They could test the most promising variants further and still leave the transformant alive. Incidentally, my profile thumbnail shows a similar assay by looking at halos of lysis around competing bacteria.
The beauty of this process is that it can be done multiple times. In the paper, Dr. Arnold did multiple rounds of directed evolution, taking the most stable version of subtilisin E each time and using the transformed bacterial strain as the source of DNA for the next round. The most active enzyme variant in dimethylformamide was named PC3 and she definitively showed that this enzyme variant was significantly more active than wild type subtilisin E in various concentrations of dimethylformamide. In the figure to the left, you can see PC3 has a higher catalytic efficiency (Kcat/Km) than WT subtilisin E.

She sequenced gene for PC3 and found ten individual point mutations in the amino acid sequence for subilisin E. Many of these point mutations had little effect on stability by themselves so it would have been almost impossible for her to find these mutations by choice. Even if she had known which mutations to make, the labor involved in generated 10 separate mutations in a single gene in 1993 would have been immense. I’d guess 6 months to a year. Instead, the random mutagenesis process Dr. Arnold performed could probably be repeated in a few months, though it’s not guaranteed to generate the same set of mutations.
Why does this deserve the Nobel Prize?
This was a completely new way of thinking about enzyme modification. Determining how an amino acid change will affect a protein’s function is still incredibly difficult and was even more challenging back then. If scientists wanted to improve upon a natural enzyme they were often looking at years of trial and error work. Instead, Dr. Arnolds new method completely bypassed this obstacle. Rather than trying to predict one or two changes that might have an effect, she could check hundreds of thousands of random mutants within days. Modern developments in genetic engineering have made precision modifications more viable, but even today this method of directed evolution is very useful. In 2017, over 5000 publications mentioned “directed evolution” 9 and many of these publications heavily use the technique in their work 10. Directed evolution has even been broadened as a research tool, with many labs using the technique to predict things like antibiotic resistance development 11 or incorporating modern tools like CRISPR 12.
Subtilisin E might not be very important, but consider how many important enzymes have been developed using the method Dr. Arnold pioneered. Important enzymes in detergents, biofuels, and medicines have been created by directed evolution 13 and many are currently in development. However, these industrial and medical applications owe a lot to the work of the other recipients of the Nobel Prize: George P. Smith and Sir Gregory P. Winter. In the next entries to this series, I’ll be covering their contributions.
References
(1) https://old.nobelprize.org/che-press.pdf?_ga=2.87232604.535716584.1538560295-715396971.1538560295
(2) https://en.wikipedia.org/wiki/Frances_Arnold
(3) http://fhalab.caltech.edu/
(4) http://www.latimes.com/science/sciencenow/la-sci-sn-nobel-prize-chemistry-evolution-20181003-story.html
(5) http://www.pnas.org/content/90/12/5618.short
(5.5) https://onlinelibrary.wiley.com/doi/full/10.1002/anie.201708408
(6) https://en.wikipedia.org/wiki/Directed_evolution
(7) @justtryme90/science-lesson-dna-testing-forensic-science-and-cutting-edge-medicine
(8) http://www.austincc.edu/microbugz/casease_test.php
(9) https://scholar.google.com/scholar?q=%22directed+evolution%22&hl=en&as_sdt=0%2C5&as_ylo=2017&as_yhi=2017
(10) https://link.springer.com/protocol/10.1007/978-1-4939-6940-1_20
(11) http://www.pnas.org/content/early/2018/05/30/1801646115.short
(12) https://www.sciencedirect.com/science/article/pii/S109671761830123X
(13) https://www.reuters.com/article/us-nobel-prize-chemistry/trio-wins-chemistry-nobel-for-work-on-antibody-drugs-smart-enzymes-idUSKCN1MD10S
Images
All images were taken either directly from the publication referenced or labeled for reuse on Google Images. If any image owner has an issue with this article, please contact me and I will address the issue.
